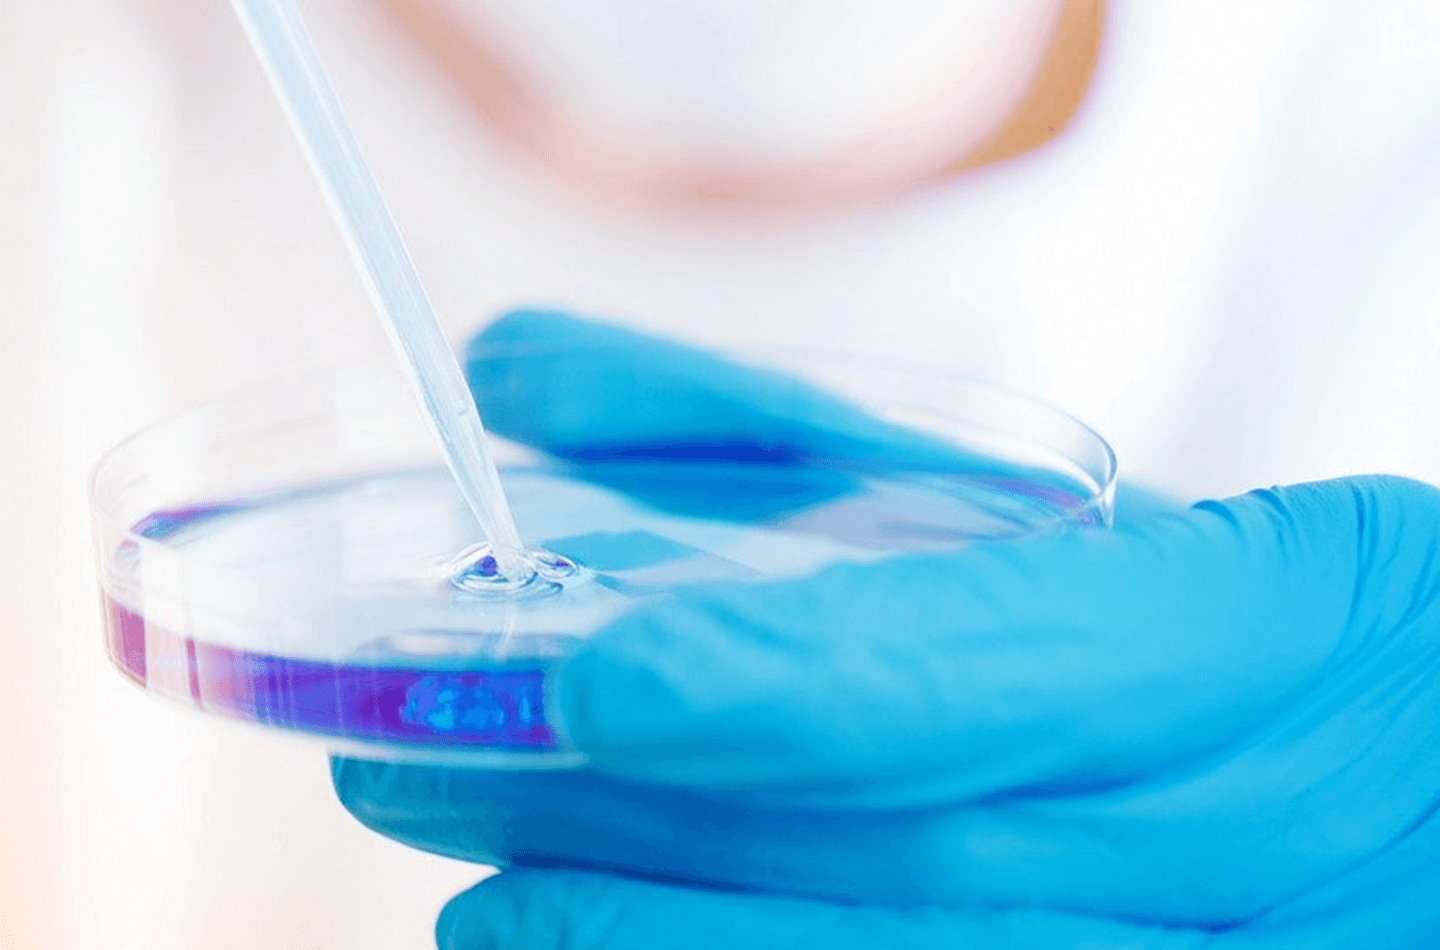

sauber und sicher
Wir warten und reinigen Lüftungsanlagen
Die aertec GmbH ist spezialisiert auf die hygienische Wartung und Reinigung von raumlufttechnischen Anlagen und Küchenabluftanlagen. Unsere Kunden aus Baugewerbe und Industrie, Gastronomie und privaten Haushalten verlassen sich seit vielen Jahren auf unsere Zuverlässigkeit und Erfahrung.
Unser Reinigungs- und Wartungsservice umfasst folgende Bereiche:
Luftkanalreinigung
Reinigung und Desinfektion von Lüftungssystemen
Dicke Luft?
Abgestandene oder gar von Stäuben, Sporen oder Krankheitserregern belastete Luft ist schlecht für die Gesundheit von Mitarbeiterinnen und Mitarbeitern und kann hohe Folgekosten nach sich ziehen. Wir führen die Luftkanalreinigung nach VDI 6022 durch.
Ein Minimalziel dieser Richtlinienreihe ist, dass die in den Raum abgegebene Luft nicht von schlechterer Qualität ist als die von der Anlage angesaugte Luft. Dazu kontrollieren wir als Erstes den Ist-Zustand des Lüftungssystems. Anschließend reinigen wir die Anlage gründlich: Schmutzablagerungen entfernen wir mit modernster Bürstentechnologie
sowie mit Druckluft und Unterdruck und führen sie mit Spezialpressluftdüsen zu einer Staubfalle.
Auf Wunsch erhalten Sie eine Videoaufzeichnung Ihrer Anlage.
Wir reinigen weiter Ventilatoren und Gitter und wechseln, wenn dies erforderlich ist, Luftfilter. Abschließend desinfizieren wir die Luftkanäle sorgfältig, um eine Kontaminierung durch Bakterien, Viren oder Sporen auch in Zukunft auszuschließen. Die durchgeführten Arbeiten dokumentieren wir ausführlich für Sie.
Auf Wunsch erhalten Sie eine Videoaufzeichnung Ihrer Anlage.
Vorgehensweise bei der Reinigung von Lüftungssystemen
Reinigung von Raumlufttechnischen Anlagen (RLT) nach VDI 6022
Reinigung von Raumlufttechnischen Anlagen (RLT) nach VDI 6022
Hygieneinspektion und Reinigung von Klimaanlagen
Klimaanlagen sind oft Fluch und Segen zugleich.
In Bürogebäuden, Industriebetrieben, Schulen und Krankenhäusern sorgen Klimaanlagen zuverlässig dafür, dass immer frische Luft in den Räumen zirkuliert.
Bei mangelhafter Wartung lagern sich jedoch Staub und mikrobiologische Schadstoffe in den Kanälen ab und bilden den Nährboden für Pilze, Schimmel und gesundheitsschädliche Gase. Dann kann es zum „Sick-Building-Syndrom“ kommen: Das Arbeiten in solchen Gebäuden macht krank.
Mitarbeiter klagen über Kopfschmerzen, Müdigkeit, Nasen-Nebenhöhlen-Reizungen, Hautirritationen und eine Vielzahl anderer Beschwerden. In schweren Fällen müssen Betriebsstätten bis zur Behebung der Ursachen geschlossen werden.
Der Gesetzgeber schreibt deshalb vor, dass Raumlufttechnische Anlagen regelmäßig inspiziert und bei Bedarf professionell gereinigt werden müssen. Nach der Richtlinie VDI 6022 muss die durch die RLT-Anlage eingeleitete Luft im Innenraum hygienisch einwandfrei sein und darf nicht schlechter sein als die Außenluft. Außerdem: Eine gereinigte Anlage ist effizienter und langlebiger, zudem birgt sie deutlich weniger Brandlast.
Fallbeispiel
Unser Kunde ist Facility Manager bei einer Versicherung. Seit einiger Zeit gibt es auffallend viele Krankmeldungen im Großraumbüro.
Die Ursache ist schnell gefunden: Die Wartungsintervalle der Klimaanlage waren nicht eingehalten worden und die Lüftungskanäle sind verschmutzt. So konnten Schadstoffe in die Raumluft gelangen, die zu Atemwegsinfekten bei den Angestellten führten. Wir reinigen und desinfizieren die gesamte Lüftungsanlage. Der Krankenstand geht signifikant zurück.
Die Ursache ist schnell gefunden: Die Wartungsintervalle der Klimaanlage waren nicht eingehalten worden und die Lüftungskanäle sind verschmutzt. So konnten Schadstoffe in die Raumluft gelangen, die zu Atemwegsinfekten bei den Angestellten führten. Wir reinigen und desinfizieren die gesamte Lüftungsanlage. Der Krankenstand geht signifikant zurück.
Reinigung einer Kontrollierten Wohnraumlüftung (KWL)
Verbesserung der Raumluftqualität – Senkung des Energiebedarfs
Es liegt was in der Luft:
Pollen sind für Allergiker eine Qual, schlechte Gerüche und Feuchtigkeit sollen nach draußen. Lüftungsanlagen für Wohnräume sind aus der modernen Haustechnik nicht wegzudenken und erlauben eine schnelle und effiziente Zufuhr von Frischluft. Sie müssen deshalb regelmäßig professionell kontrolliert und gereinigt werden, denn sonst lagern sich Schadstoffe in den Kanälen ab und können bei den Hausbewohnern Allergien und schwerwiegende Krankheiten auslösen (Sick-Building-Syndrom). Bei einem solchen Verdacht entnehmen wir mikrobiologische Proben und werten sie zusammen mit einem zertifizierten Hygieneinstitut auf Schadstoffe aus.
Wir führen die Reinigung der Kontrollierten Wohnraumlüftung (KWL) professionell durch, inspizieren das Lüftungssystem und alle Elemente wie Ventilatoren und Wärmetauscher, wechseln die Filter und desinfizieren auf Wunsch die gesamte Anlage. Damit Sie wieder durchatmen können.
So sorgt die Kontrollierte Wohnraumlüftung für optimale Raumluftqualität
Fallbeispiel
Unser Kunde ist Eigentümer eines Einfamilienhauses. Seit einiger Zeit beobachtet er Schimmelbildung in den Nassräumen, außerdem ist die Luft in den Wohnräumen – trotz häufigem Lüften - schlechter geworden.
Wir stellen fest: Die Kontrollierte Wohnraumlüftung wurde seit der Fertigstellung des Hauses vor 10 Jahren noch nie gereinigt, außerdem befinden sich Katzenhaare in den Lüftungskanälen, die die Luftzirkulation stark behindern. Wir reinigen das gesamte Lüftungsnetz.
Rückmeldung des Kunden: Es gibt keine Schimmelbildung mehr und die Raumluft ist wieder frisch.
Wir stellen fest: Die Kontrollierte Wohnraumlüftung wurde seit der Fertigstellung des Hauses vor 10 Jahren noch nie gereinigt, außerdem befinden sich Katzenhaare in den Lüftungskanälen, die die Luftzirkulation stark behindern. Wir reinigen das gesamte Lüftungsnetz.
Rückmeldung des Kunden: Es gibt keine Schimmelbildung mehr und die Raumluft ist wieder frisch.
Reinigung von Schachtlüftungen
nach DIN 18017-3
+ DIN 18017-1
nach DIN 18017-3
+ DIN 18017-1
Saubere Entlüftung von fensterlosen Bädern und Toiletten
Muffige, stickige Kammern sind von gestern:
In modernen Wohngebäuden und Hotels sorgt eine Lüftungsanlage mit Ventilatoren für Frischluftzufuhr in innenliegende Räume, z.B. Toiletten, Bäder, Küchen oder Abstellräume.
Auch diese Anlagen müssen regelmäßig gewartet und gereinigt werden, damit sie hygienisch einwandfrei funktionieren. Wenn die Frischluftzufuhr gestört ist, besteht in Bädern besonders die Gefahr der Schimmelbildung und damit eine massive gesundheitliche Gefährdung der Bewohner.
Wir setzen für die Inspektion von Schachtlüftungen verschiedene Messgeräte ein, z.B. führen wir eine Volumenstrommessung durch, um die Durchlässigkeit der Lüftungsgitter zu prüfen.
Lüftung über ein Schachtsystem ohne Ventilatoren
Fallbeispiel
Unser Kunde ist Hausverwalter eines Hochhauses. Eine Mietpartei beklagt sich über massive Geruchsbelästigung
durch Fäkalgerüche in ihrer Wohnung.
Die Volumenstrommessung bringt ans Licht: Im Lüftungsschacht, der alle Wohnungen verbindet, zirkuliert zu viel Luft. Ursache ist eine neue Dunstabzugshaube mit Abluftventilatoren, die der Besitzer der darunter liegenden Wohnung in Eigenregie eingebaut hatte. Diese ist aus Sicherheitsgründen unzulässig. Sie muss umgerüstet werden. Wir entfernen den Ventilator und reinigen die Schachtlüftung. Das Problem ist auf der Stelle behoben.
Die Volumenstrommessung bringt ans Licht: Im Lüftungsschacht, der alle Wohnungen verbindet, zirkuliert zu viel Luft. Ursache ist eine neue Dunstabzugshaube mit Abluftventilatoren, die der Besitzer der darunter liegenden Wohnung in Eigenregie eingebaut hatte. Diese ist aus Sicherheitsgründen unzulässig. Sie muss umgerüstet werden. Wir entfernen den Ventilator und reinigen die Schachtlüftung. Das Problem ist auf der Stelle behoben.
Reinigung von Küchenabluftanlagen
nach VDI 2052
nach VDI 2052
Gesundes Arbeitsklima - Vorbeugender Brandschutz – Hygienische Sauberkeit
Nehmen Sie den Begriff „Arbeitsklima“ ruhig wörtlich.
Der Austausch verbrauchter, fettiger und feuchter Luft durch Frischluft ist gerade in Küchen essenziell. Ihre Mitarbeiterinnen und Mitarbeiter werden es Ihnen danken – und Ihr Geldbeutel, denn eine Reinigung von Abluftanlagen senkt die Stromkosten! Fett in Dunstabzugsanlagen ist entzündlich. Aus Brandschutzgründen ist deshalb eine regelmäßige Inspektion und Reinigung unerlässlich. Diese dokumentieren wir sorgfältig, damit Sie im Schadensfall auf der sicheren Seite sind.
Als Gastronom wissen Sie, wie wichtig es ist, Hygienevorschriften einzuhalten.
Verschmutzungen an Abzugshauben, Abluftleitungen und Ventilatoren beseitigen wir zuverlässig. En Guete!
Reinigung einer Dunstabzugsanlage mit dem Trockendampfverfahren
Hygiene-Inspektion für Lüftungsanlagen
Liegt etwas in der Luft?
Schwachstellen frühzeitig erkennen und beseitigen
Eine Lüftungsanlage muss regelmäßig gewartet werden, denn nur so ist gewährleistet, dass sie alle hygienischen Voraussetzungen erfüllt und energetisch optimal funktioniert. Wir bieten unseren Kunden einen präventiven Hygiene-Check an. Vor Ort nehmen wir eine Sichtprüfung aller Komponenten Ihrer Lüftungsanlage vor. Wenn Handlungsbedarf besteht, beraten wir Sie kompetent zu den notwendigen Schritten und erarbeiten mit Ihnen eine auf Ihre individuelle Situation angepasste Lösung.